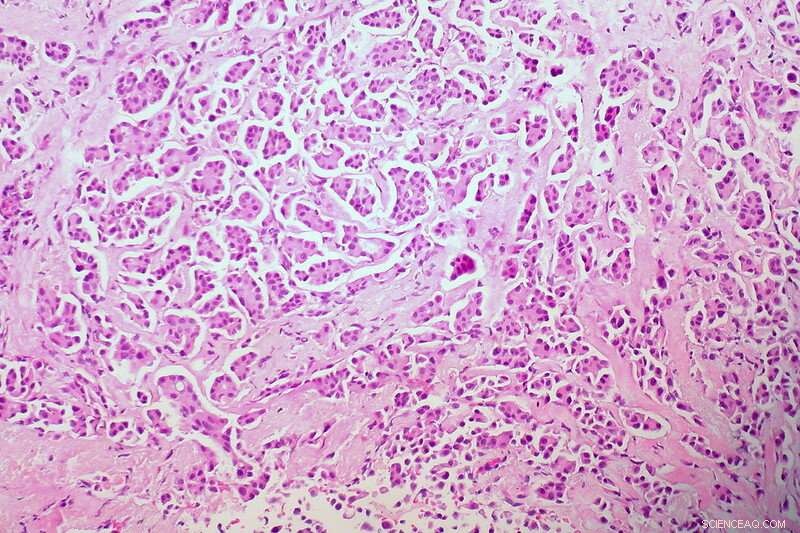
Chip‑Scale Microscopes: Expanding Expert Diagnostics to Remote Patients

Scientists are reducing the size and costs of microscopes, which could make this equipment more widely accessible and facilitate faster diagnosis of diseases such as cancer. Credit: Ed Uthman/Flickr, licenced under CC0 1.0
Scientists are reducing the size and costs of medical microscopes to make it possible to use them more widely, and hook them up to experts able to diagnose an illness even from far away.
Falling ill in a remote part of the world can mean difficulty in finding the right care. Even where medical help may be available, it may be impossible to get a definitive diagnosis because of a lack of specialist expertise and laboratory equipment, such as microscopes.
Advanced miniaturisation means patients could benefit from a 'microscope on a chip," according to Dr. Angel Dieguez, senior lecturer in the Department of Electronics and Biomedical Engineering at the University of Barcelona, Spain.
He runs a project called ChipScope, which uses some of the smallest light sources ever manufactured to push the limits of conventional optics, in a device potentially compact enough to fit in a pocket.
"It may be possible for a modified mobile phone to have images of the nano-world," Dr. Dieguez said.
Shadow images
ChipScope's prototype illuminates a tissue sample using an array of minute light emitting diodes (LEDs) – among the smallest ever manufactured—to create shadow images of the specimen. These images are then captured using a detector sensitive enough to detect single photons and processed to produce a complete picture.
Through very precise control of these LEDs, which are about 1,000 times smaller than the diameter of a human hair, the ChipScope imaging system has a spatial resolution of just below 200 nanometres—which is the usual limit with visible light.
ChipScope's microscope works by using some of the smallest light emitting diodes ever manufactured to create shadow images of the specimen. Image credit—TU Braunschweig
'(By) triggering these tiny LEDs individually, and in sequence, we can add together the shadow images to build up a picture of the sample," Dr. Dieguez said.
Given the practicalities of positioning tissue specimens or bacteria on such a tiny detector, ChipScope is working on a small analysis tool to position the sample between the LEDs and the sensor.
The mechanism under development uses a minute amount of liquid and high-precision pumps to manipulate the sample through channels in a plastic slide and into the field of view, which is about 10 microns—just under the size of an average human cell.

ChipScope’s microscope works by using some of the smallest light emitting diodes ever manufactured to create shadow images of the specimen. Credit: TU Braunschweig
The microscope could also be used to identify and study pathogens, such as tuberculosis bacteria in a patient's sputum.
But outside the mobile medical field, ChipScope could play a role in environmental monitoring, such as in assessing water quality or examining particulate matter in polluted air, Dr. Dieguez says.
It could readily provide images of airborne nanoparticles, including those smaller than 2.5 microns, considered the most dangerous to human health.
Dr. Dieguez estimates the microscope and control electronics cost less than €1,000 for the prototype being developed, and that further development and economies of scale could bring this down to as little as €10 or so.
While ChipScope shrinks the light sources and captures a specimen's shadows, another novel system, developed by Grundium of Finland, uses repeat scans with coloured light to assemble a digital picture that can then be analysed by a specialist or intelligent diagnostic software.
"Anybody who can prepare a slide can use the technology."
Mika Kuisma, CEO, Grundium
Red, green and blue
The Grundium digital scanning microscope makes high resolution scans of a tissue sample—done separately in red, green and blue light—which can then be combined to analyse samples at different layers, as well as maximise the resolution and level of detail.
The digital images can be displayed on any device with an internet connection and a web browser, for analysis onsite or shared online to be studied anywhere in the world. The system produces images in a range of digital formats compatible with sophisticated diagnostics applications that can recognise patterns of infection or signatures of disease, such as cancer, which can sometimes be missed by even the best-trained human eye.
Intelligent diagnostics is a major growth area in digital medicine, given a global shortage of pathologists and the increased need for tissue analysis—as demonstrated by the explosion in demand for such expertise in the global COVID-19 pandemic.
Grundium's approach is to develop and combine hardware, optics and software to work together, chief executive Mika Kuisma said, rather than adapting a conventional, analogue system to the digital world.

Grundium’s microscope produces digital images that can be analysed onsite or shared online to be studied anywhere in the world. Credit: Mikko Malmivaara, Grundium Ltd
He estimates only about 20% of potential users such as pathology laboratories and small- or medium-sized clinics have access to digital scanning tools, and that bringing down the costs and size of the equipment can open the door wider to digital pathology.
"We are trying to democratise the access to professional diagnostics services," said Kuisma, an engineer formerly at mobile telecommunications company Nokia.
"The potential is enormous," he added, noting that the company sees a market of about 10,000 small- and medium-sized clinics or pathology laboratories just in Europe and North America and a global market of about €5 billion by 2023.
Once the samples have been scanned and their images saved and stored, all the necessary information is available for diagnosis, with no need to preserve or transport the original sample to a distant laboratory.
Grundium's microscope produces digital images that can be analysed onsite or shared online to be studied anywhere in the world. Image credit—Mikko Malmivaara, Grundium Ltd
Kenya
In a pilot of this approach, Grundium has worked with a clinic in rural Kenya since 2018 to diagnose cervical cancer. Clinic staff use the microscope to scan tissue samples and the images are then shared online to be instantly available for examination by a pathologist in Helsinki, Finland. By working with local health authorities, Kuisma believes the results will help patients get better treatment.
Grundium's products are on the market for about €15,000, but Kuisma sees this coming down with economies of scale and expects to offer a product for less than €10,000 in the next few years. That compares with existing systems that can cost 20 times as much.
While that may still be out of reach for smaller clinics in developing countries, Grundium sees scope for collaboration in those circumstances with capable partners—and the possibility of special rates where the technology could be of benefit.
Sample preparation costs just a few cents, the same as for any optical microscope, and does not require a medical specialist, Kuisma said, adding that other potential applications include systems for use in veterinary medicine.
"Anybody who can prepare a slide can use the technology," he added.
By putting the technology within the reach of clinics and small or medium-sized hospitals, he sees potential for linking patients with smart diagnostics and medical expertise that would otherwise be out of reach.